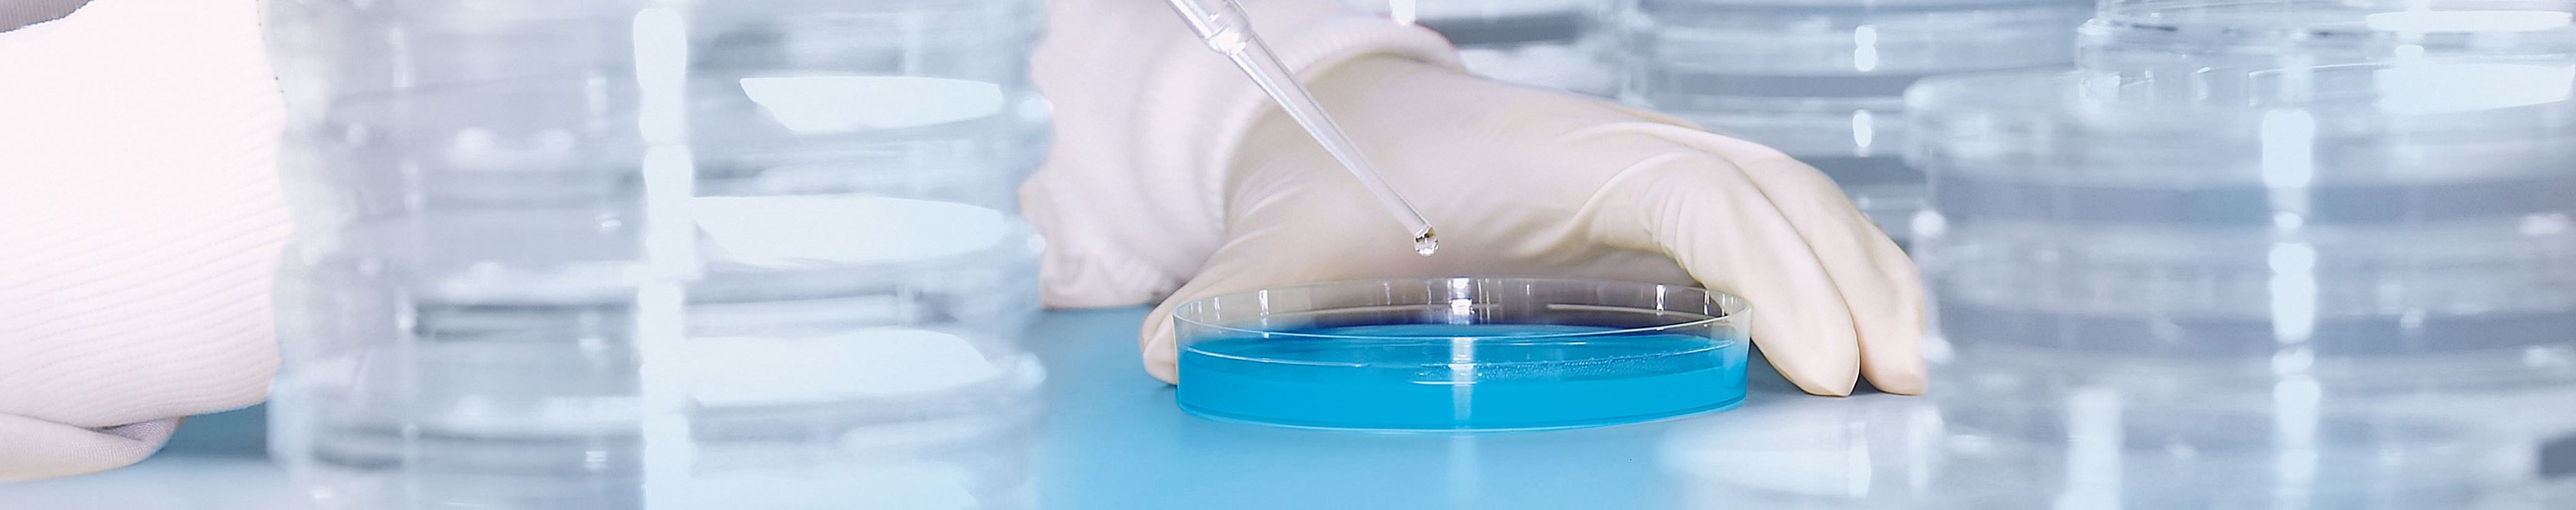
Hygienelabor.jpg Hygienelabor.jpg
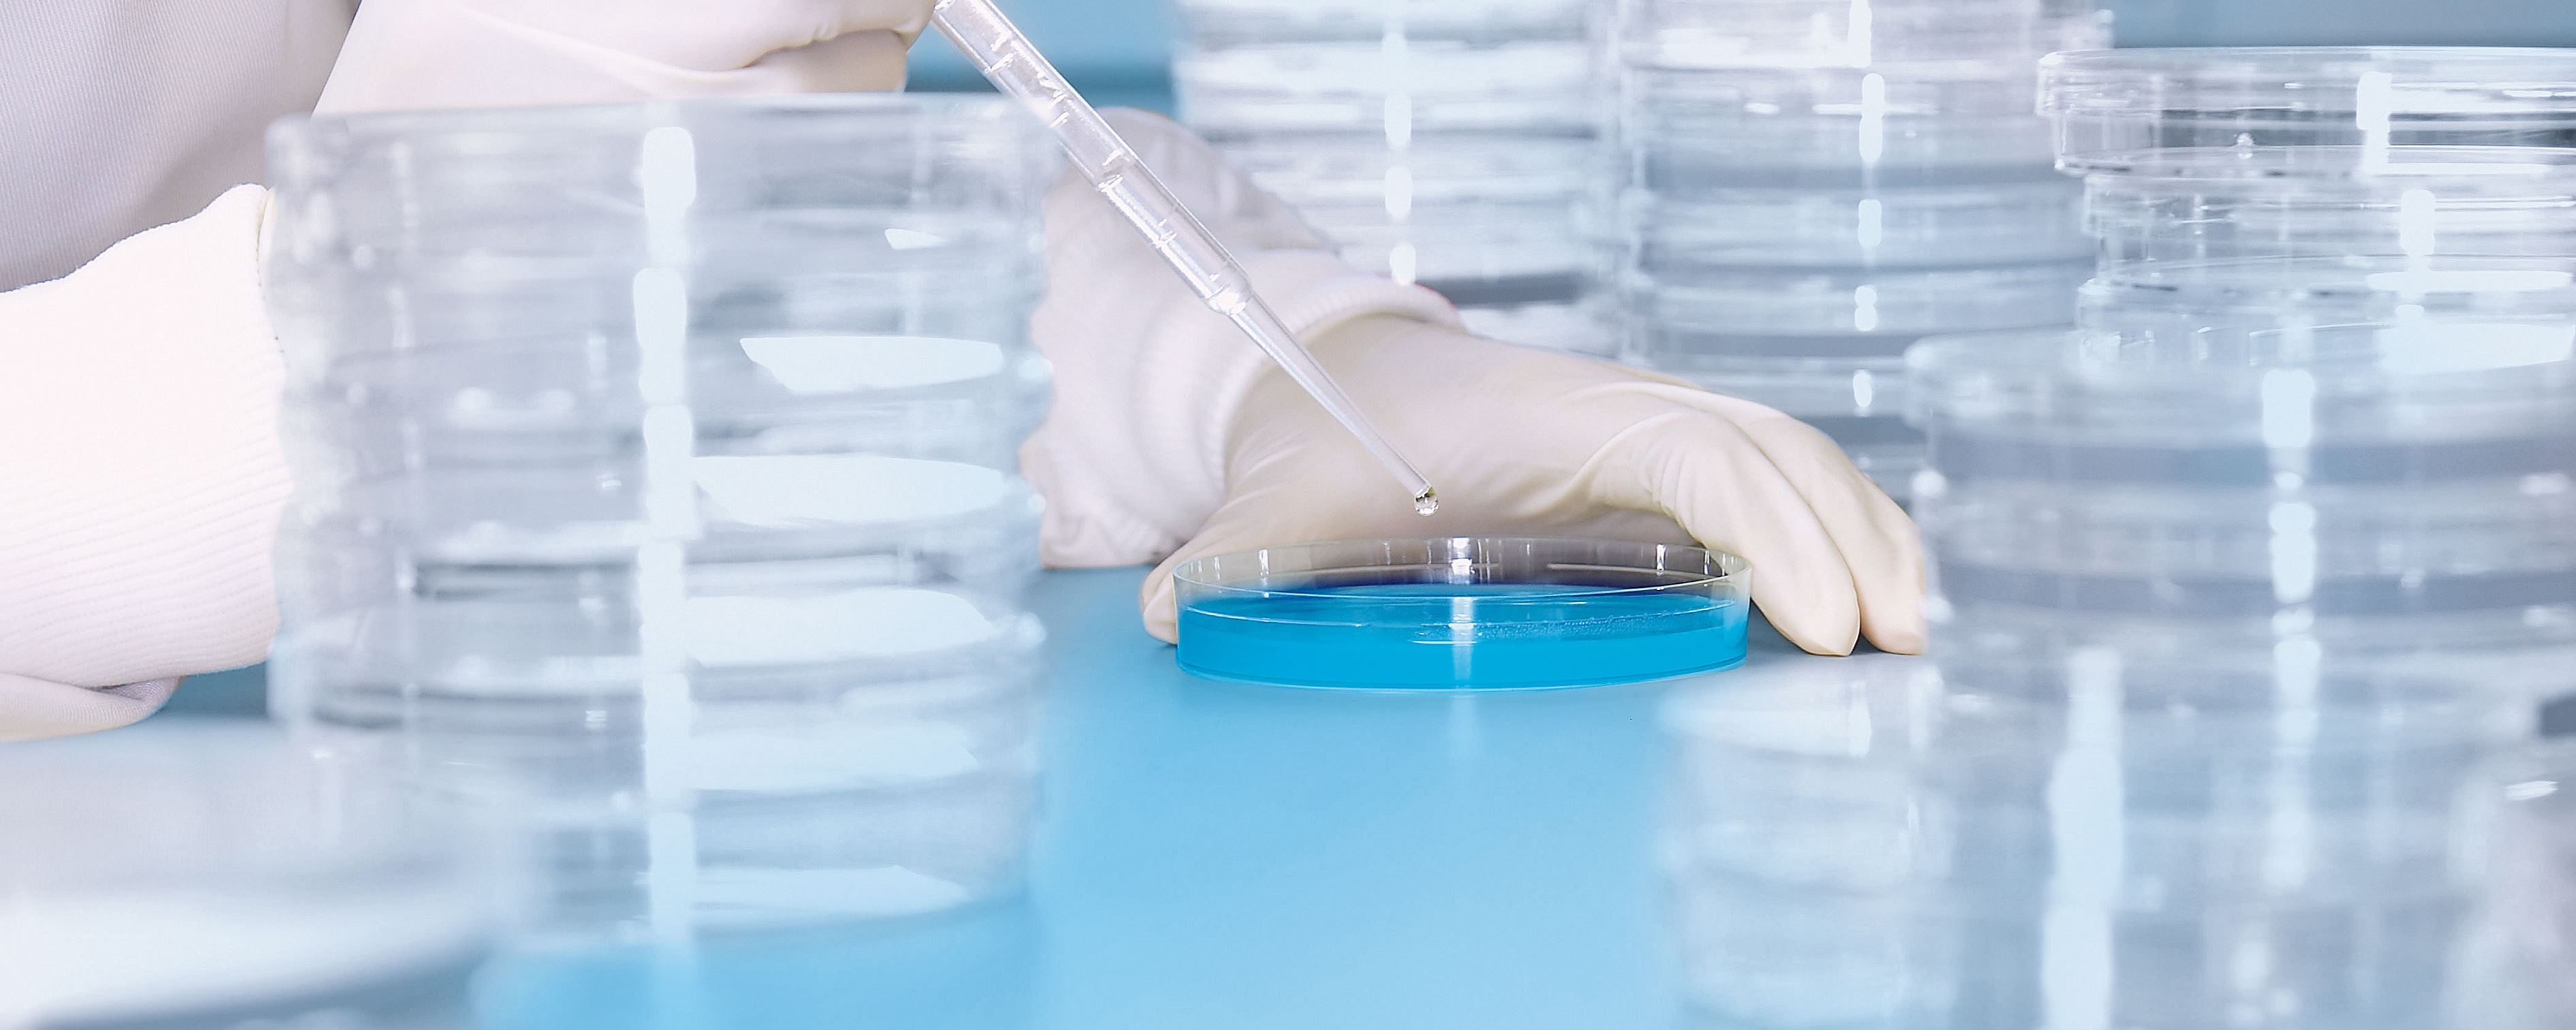
Hygienelabor.jpg Hygienelabor.jpg
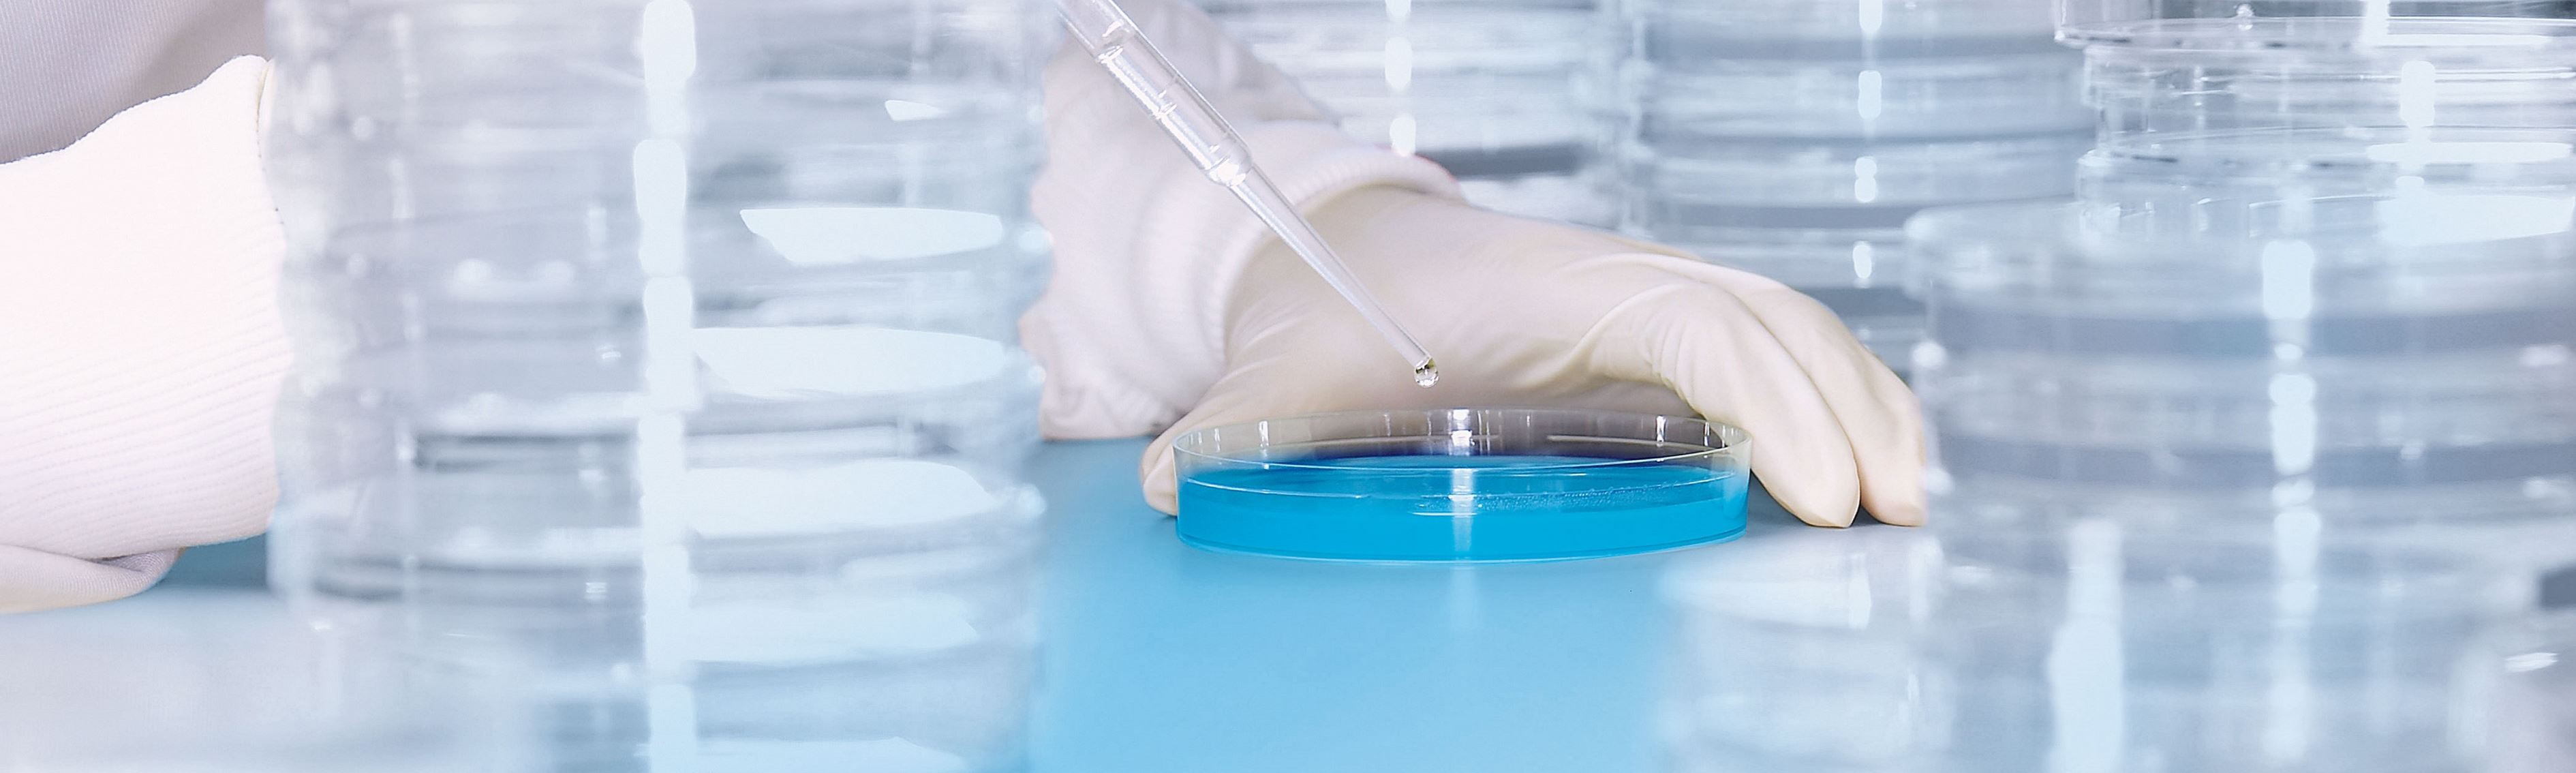
Hygienelabor.jpg Hygienelabor.jpg

Ein vollständiges und umfassendes Hygienekonzept ermöglicht, Gegebenheiten zu analysieren und zu verändern. Das Hygieneverhalten der Mitarbeitenden ist genau festgelegt, kann jederzeit überprüft und bei Bedarf angepasst werden. Als Hygienespezialisten behalten wir die komplette Hygienekette im Auge. Wir von der Enzler Hygiene AG zeigen Handlungsbedarf und Verbesserungspotenzial auf und unterstützen Sie beim Erstellen der Dokumentation.